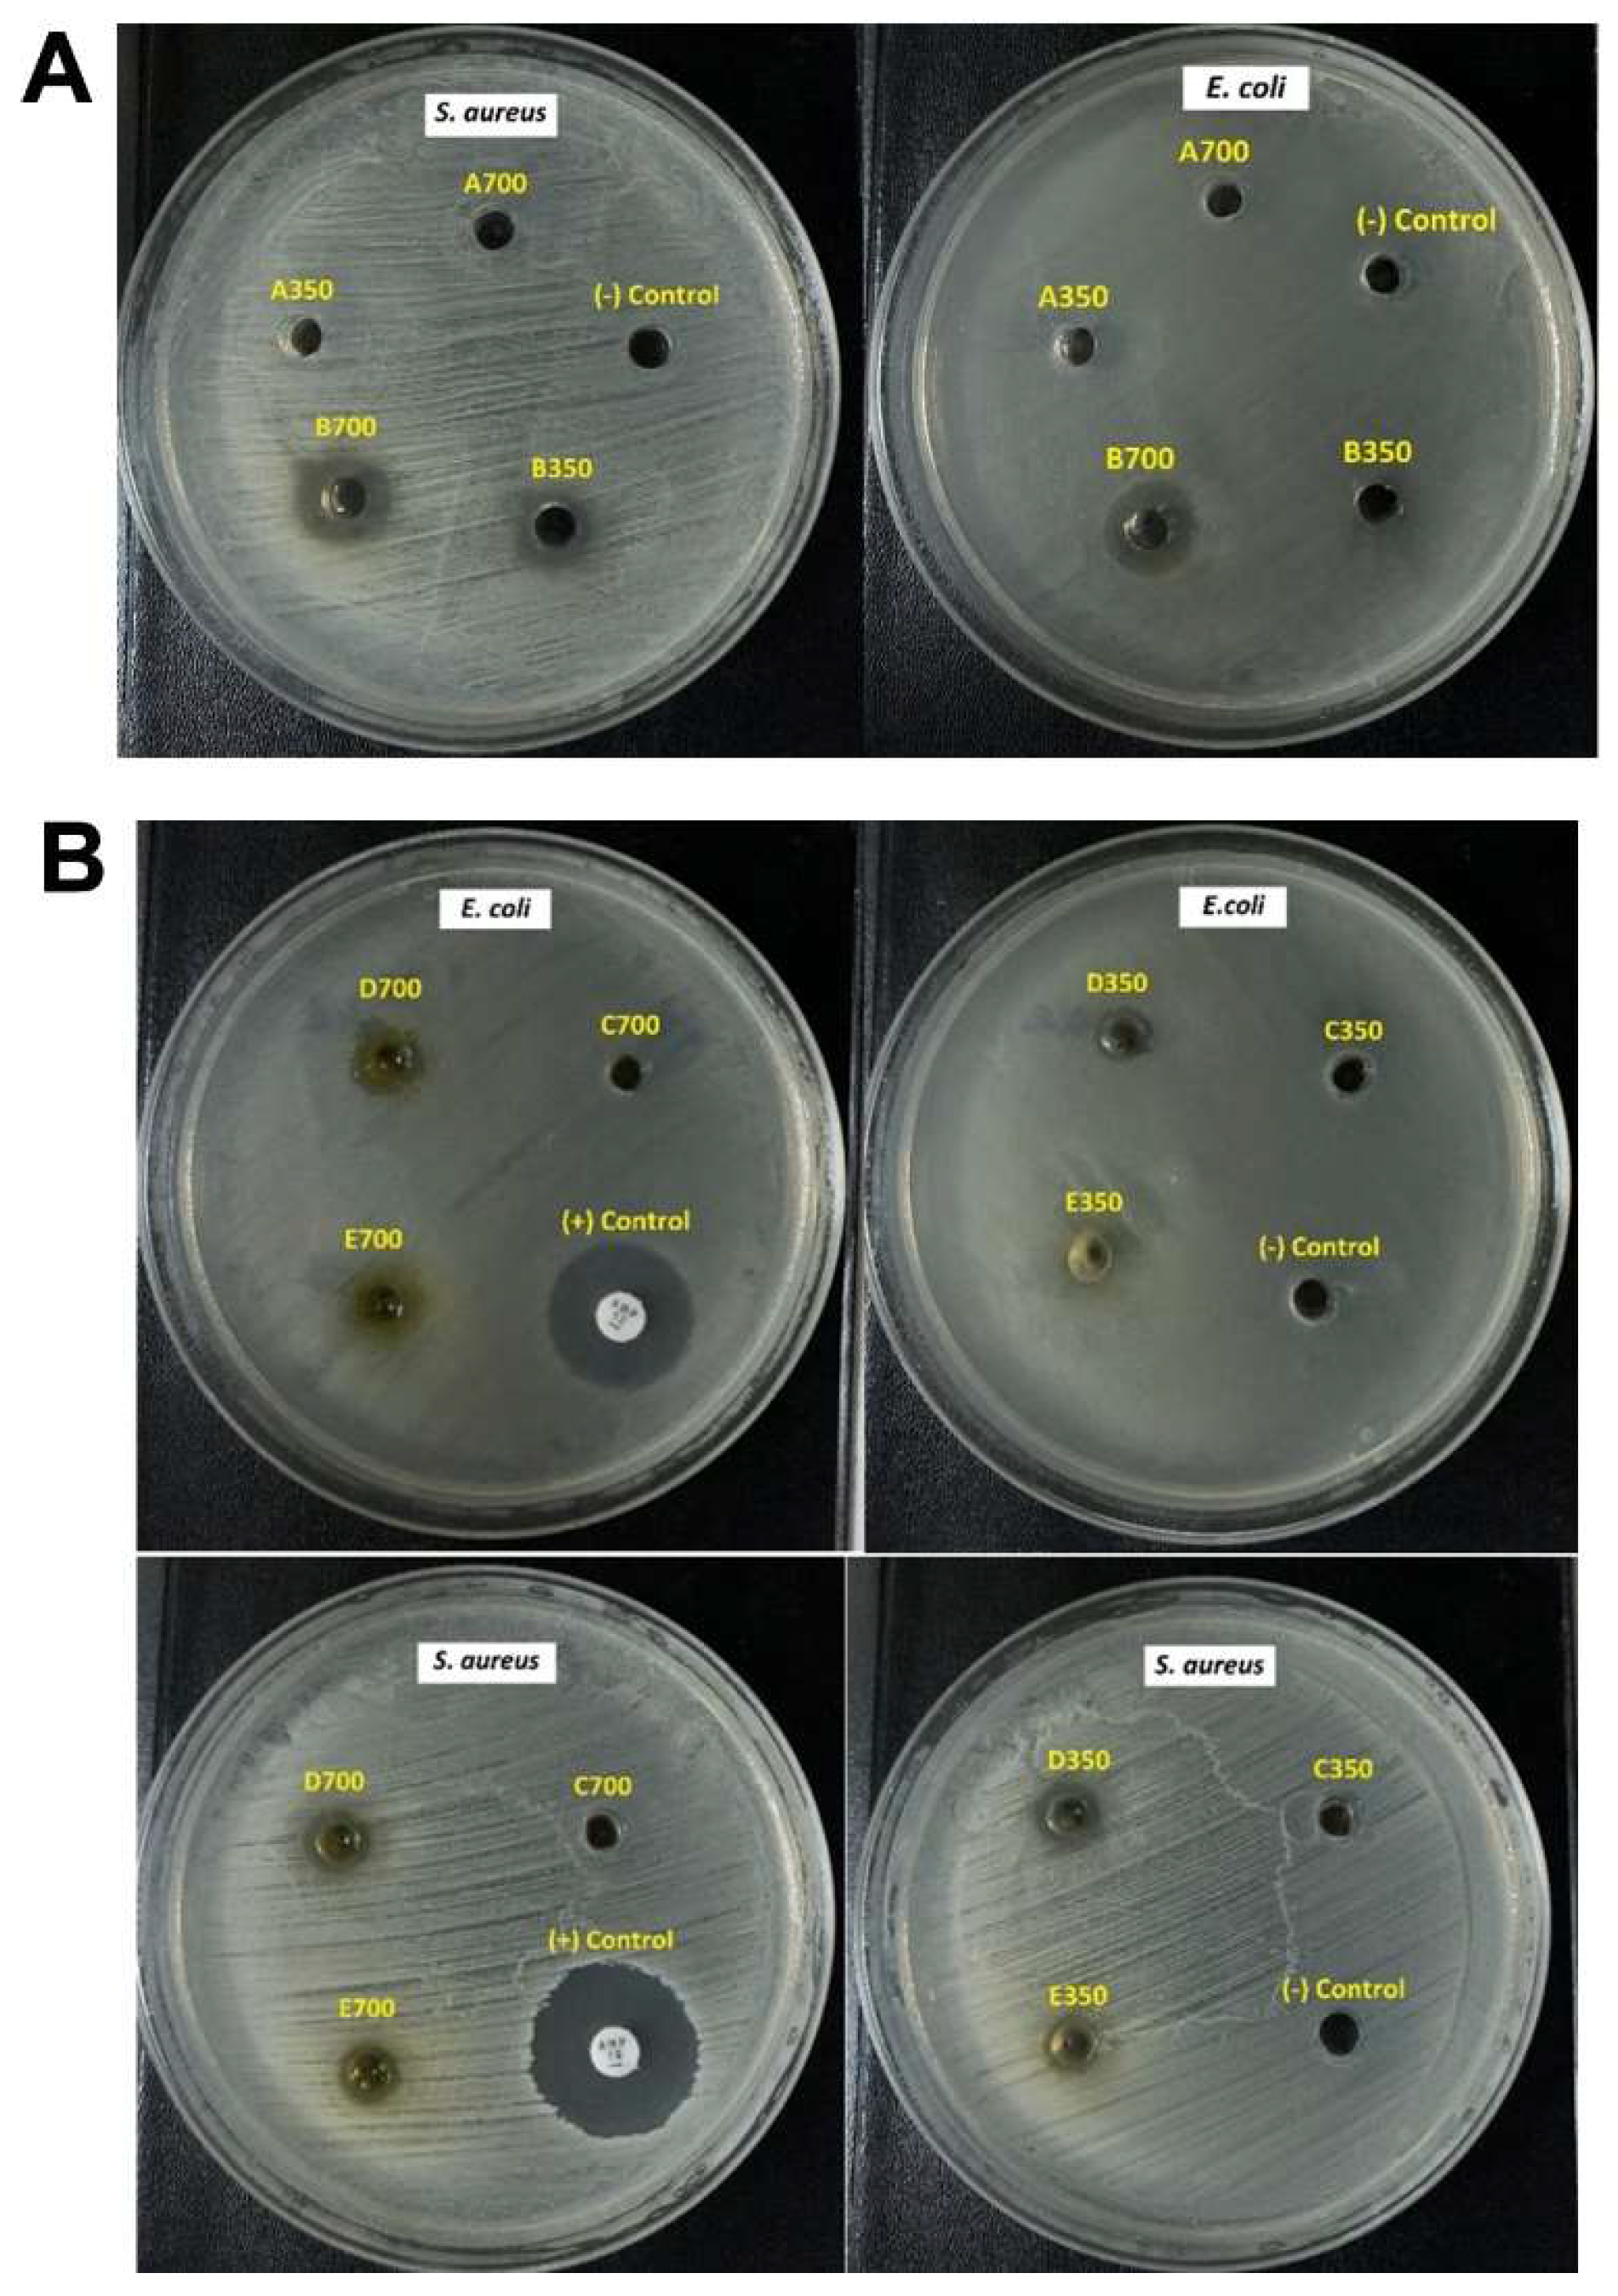
Molecules 28 06433 g004

Development and Characterization of a Hydrogel Containing Curcumin-Loaded Nanoemulsion for Enhanced In Vitro Antibacteria and In Vivo Wound Healing
Abstract
:1. Introduction
2. Results
2.1. The Saturation Solubility of CUR in Different Excipients
2.2. Emulsification Efficiency
2.3. Construction of Ternary Phase Diagrams
2.4. Optimization of CUR-Loaded NE
2.5. The Effects of Factors on Droplet Size and Droplet Size Distribution
2.6. Characterization of CUR-Loaded NE and CUR-NE Gel
2.7. In Vitro Antimicrobial Activity
2.8. In Vivo Wound Healing Study
2.9. Histopathological Study
3. Discussion
4. Materials and Methods
4.1. Materials
4.2. Methods
4.2.1. Assessment of the Saturation Solubility of CUR in Different Excipients
4.2.2. Evaluation of Emulsification Efficiency
4.2.3. Construction of Ternary Phase Diagrams
4.2.4. Optimization of CUR-Loaded NE
4.2.5. Formulation of CUR-NE-Based Gel
4.3. Characterization of CUR-Containing NE
4.3.1. Appearance
4.3.2. Droplet Size and Size Distribution
4.3.3. Particle Morphology
4.3.4. Dynamic Stability
4.3.5. Assay for Drug Content
4.4. Characterization of CUR-NE Gel
4.4.1. Visual Appearance and pH
4.4.2. In Vitro Drug Release
4.4.3. In Vitro Antimicrobial Activity
4.4.4. In Vivo Wound Healing Study
4.4.5. Histopathological Study
4.4.6. Statistical Analysis
5. Conclusions
Supplementary Materials
Author Contributions
Funding
Institutional Review Board Statement
Informed Consent Statement
Data Availability Statement
Acknowledgments
Conflicts of Interest
Sample Availability
References
- Sharifi, S.; Fathi, N.; Memar, M.Y.; Hosseiniyan Khatibi, S.M.; Khalilov, R.; Negahdari, R.; Zununi Vahed, S.; Maleki Dizaj, S. Anti-microbial activity of curcumin nanoformulations: New trends and future perspectives. Phytother. Res. 2020, 34, 1926–1946. [Google Scholar] [CrossRef] [PubMed]
- Prasad, S.; Tyagi, A.K.; Aggarwal, B.B. Recent developments in delivery, bioavailability, absorption and metabolism of curcumin: The golden pigment from golden spice. Cancer Res. Treat. 2014, 46, 2–18. [Google Scholar] [CrossRef]
- Hettiarachchi, S.S.; Perera, Y.; Dunuweera, S.P.; Dunuweera, A.N.; Rajapakse, S.; Rajapakse, R.M.G. Comparison of Antibacterial Activity of Nanocurcumin with Bulk Curcumin. ACS Omega 2022, 7, 46494–46500. [Google Scholar] [CrossRef]
- Adahoun, M.A.; Al-Akhras, M.H.; Jaafar, M.S.; Bououdina, M. Enhanced anti-cancer and antimicrobial activities of curcumin nanoparticles. Artif. Cells Nanomed. Biotechnol. 2017, 45, 98–107. [Google Scholar] [CrossRef]
- Salehi, B.; Rodrigues, C.F.; Peron, G.; Dall’Acqua, S.; Sharifi-Rad, J.; Azmi, L.; Shukla, I.; Singh Baghel, U.; Prakash Mishra, A.; Elissawy, A.M.; et al. Curcumin nanoformulations for antimicrobial and wound healing purposes. Phytother. Res. 2021, 35, 2487–2499. [Google Scholar] [CrossRef]
- Gao, M.; Long, X.; Du, J.; Teng, M.; Zhang, W.; Wang, Y.; Wang, X.; Wang, Z.; Zhang, P.; Li, J. Enhanced curcumin solubility and antibacterial activity by encapsulation in PLGA oily core nanocapsules. Food Funct. 2020, 11, 448–455. [Google Scholar] [CrossRef]
- Leng, Q.; Li, Y.; Pang, X.; Wang, B.; Wu, Z.; Lu, Y.; Xiong, K.; Zhao, L.; Zhou, P.; Fu, S. Curcumin nanoparticles incorporated in PVA/collagen composite films promote wound healing. Drug Deliv. 2020, 27, 1676–1685. [Google Scholar] [CrossRef]
- Sadeghi-Ghadi, Z.; Behjou, N.; Ebrahimnejad, P.; Mahkam, M.; Goli, H.R.; Lam, M.; Nokhodchi, A. Improving Antibacterial Efficiency of Curcumin in Magnetic Polymeric Nanocomposites. J. Pharm. Innov. 2022, 18, 13–28. [Google Scholar] [CrossRef]
- Kianvash, N.; Bahador, A.; Pourhajibagher, M.; Ghafari, H.; Nikoui, V.; Rezayat, S.M.; Dehpour, A.R.; Partoazar, A. Evaluation of propylene glycol nanoliposomes containing curcumin on burn wound model in rat: Biocompatibility, wound healing, and anti-bacterial effects. Drug Deliv. Transl. Res. 2017, 7, 654–663. [Google Scholar] [CrossRef] [PubMed]
- Jourghanian, P.; Ghaffari, S.; Ardjmand, M.; Haghighat, S.; Mohammadnejad, M. Sustained release Curcumin loaded Solid Lipid Nanoparticles. Adv. Pharm. Bull. 2016, 6, 17–21. [Google Scholar] [CrossRef]
- Barros, C.H.N.; Hiebner, D.W.; Fulaz, S.; Vitale, S.; Quinn, L.; Casey, E. Synthesis and self-assembly of curcumin-modified amphiphilic polymeric micelles with antibacterial activity. J. Nanobiotechnol. 2021, 19, 104. [Google Scholar] [CrossRef]
- Roy, A.; Nishchaya, K.; Rai, V.K. Nanoemulsion-based dosage forms for the transdermal drug delivery applications: A review of recent advances. Expert Opin. Drug Deliv. 2022, 19, 303–319. [Google Scholar] [CrossRef]
- Gupta, A.; Eral, H.B.; Hatton, T.A.; Doyle, P.S. Nanoemulsions: Formation, properties and applications. Soft Matter 2016, 12, 2826–2841. [Google Scholar] [CrossRef]
- Dhawan, B.; Aggarwal, G.; Harikumar, S. Enhanced transdermal permeability of piroxicam through novel nanoemulgel formulation. Int. J. Pharm. Investig. 2014, 4, 65–76. [Google Scholar] [CrossRef]
- Yang, M.; Gu, Y.; Yang, D.; Tang, X.; Liu, J. Development of triptolide-nanoemulsion gels for percutaneous administration: Physicochemical, transport, pharmacokinetic and pharmacodynamic characteristics. J. Nanobiotechnol. 2017, 15, 88. [Google Scholar] [CrossRef]
- Ahmad, N.; Ahmad, R.; Al-Qudaihi, A.; Alaseel, S.E.; Fita, I.Z.; Khalid, M.S.; Pottoo, F.H. Preparation of a novel curcumin nanoemulsion by ultrasonication and its comparative effects in wound healing and the treatment of inflammation. RSC Adv. 2019, 9, 20192–20206. [Google Scholar] [CrossRef]
- Kole, S.S.; Gotmare, V.D.; Athawale, R.B. Novel approach for development of eco-friendly antimicrobial textile material for health care application. J. Text. Inst. 2018, 110, 254–266. [Google Scholar] [CrossRef]
- Ali, M.; Khan, N.R.; Subhan, Z.; Mehmood, S.; Amin, A.; Rabbani, I.; Rehman, F.U.; Basit, H.M.; Syed, H.K.; Khan, I.U.; et al. Novel Curcumin-Encapsulated alpha-Tocopherol Nanoemulsion System and Its Potential Application for Wound Healing in Diabetic Animals. BioMed Res. Int. 2022, 2022, 7669255. [Google Scholar] [CrossRef]
- Algahtani, M.S.; Ahmad, M.Z.; Ahmad, J. Nanoemulsion loaded polymeric hydrogel for topical delivery of curcumin in psoriasis. J. Drug Deliv. Sci. Technol. 2020, 59, 101847. [Google Scholar] [CrossRef]
- Algahtani, M.S.; Ahmad, M.Z.; Nourein, I.H.; Albarqi, H.A.; Alyami, H.S.; Alyami, M.H.; Alqahtani, A.A.; Alasiri, A.; Algahtani, T.S.; Mohammed, A.A.; et al. Preparation and Characterization of Curcumin Nanoemulgel Utilizing Ultrasonication Technique for Wound Healing: In Vitro, Ex Vivo, and In Vivo Evaluation. Gels 2021, 7, 213. [Google Scholar] [CrossRef]
- Nguyen, T.K.N. Optimization of Nanoemulsion Containing Curcumin (in Vietnamese). Bachelor’s Thesis, University of Medicine and Pharmacy, Hue University, Hue, Vietnam, 2022. [Google Scholar]
- Rachmawati, H.; Budiputra, D.K.; Mauludin, R. Curcumin nanoemulsion for transdermal application: Formulation and evaluation. Drug Dev. Ind. Pharm. 2015, 41, 560–566. [Google Scholar] [CrossRef]
- Rai, V.K.; Mishra, N.; Yadav, K.S.; Yadav, N.P. Nanoemulsion as pharmaceutical carrier for dermal and transdermal drug delivery: Formulation development, stability issues, basic considerations and applications. J. Control. Release 2018, 270, 203–225. [Google Scholar] [CrossRef]
- Kumar, N.; Shishu. D-optimal experimental approach for designing topical microemulsion of itraconazole: Characterization and evaluation of antifungal efficacy against a standardized Tinea pedis infection model in Wistar rats. Eur. J. Pharm. Sci. 2015, 67, 97–112. [Google Scholar] [CrossRef]
- Fouad, S.A.; Basalious, E.B.; El-Nabarawi, M.A.; Tayel, S.A. Microemulsion and poloxamer microemulsion-based gel for sustained transdermal delivery of diclofenac epolamine using in-skin drug depot: In vitro/in vivo evaluation. Int. J. Pharm. 2013, 453, 569–578. [Google Scholar] [CrossRef] [PubMed]
- Sarheed, O.; Dibi, M.; Ramesh, K. Studies on the Effect of Oil and Surfactant on the Formation of Alginate-Based O/W Lidocaine Nanocarriers Using Nanoemulsion Template. Pharmaceutics 2020, 12, 1223. [Google Scholar] [CrossRef] [PubMed]
- Asabuwa Ngwabebhoh, F.; Ilkar Erdagi, S.; Yildiz, U. Pickering emulsions stabilized nanocellulosic-based nanoparticles for coumarin and curcumin nanoencapsulations: In vitro release, anticancer and antimicrobial activities. Carbohydr. Polym. 2018, 201, 317–328. [Google Scholar] [CrossRef] [PubMed]
- Silva, A.C.d.; Santos, P.D.d.F.; Silva, J.T.d.P.; Leimann, F.V.; Bracht, L.; Gonçalves, O.H. Impact of curcumin nanoformulation on its antimicrobial activity. Trends Food Sci. Technol. 2018, 72, 74–82. [Google Scholar] [CrossRef]
- Krausz, A.E.; Adler, B.L.; Cabral, V.; Navati, M.; Doerner, J.; Charafeddine, R.A.; Chandra, D.; Liang, H.; Gunther, L.; Clendaniel, A.; et al. Curcumin-encapsulated nanoparticles as innovative antimicrobial and wound healing agent. Nanomedicine 2015, 11, 195–206. [Google Scholar] [CrossRef]
- Lopez-Jornet, P.; Camacho-Alonso, F.; Gomez-Garcia, F.; Molina Minano, F.; Canas, X.; Serafin, A.; Castillo, J.; Vicente-Ortega, V. Effects of potassium apigenin and verbena extract on the wound healing process of SKH-1 mouse skin. Int. Wound J. 2014, 11, 489–495. [Google Scholar] [CrossRef]
- Nguyen, V.L.; Truong, C.T.; Nguyen, B.C.Q.; Vo, T.V.; Dao, T.T.; Nguyen, V.D.; Trinh, D.T.; Huynh, H.K.; Bui, C.B. Anti-inflammatory and wound healing activities of calophyllolide isolated from Calophyllum inophyllum Linn. PLoS ONE 2017, 12, e0185674. [Google Scholar] [CrossRef]
- Hadagali, M.D.; Chua, L.S. The anti-inflammatory and wound healing properties of honey. Eur. Food Res. Technol. 2014, 239, 1003–1014. [Google Scholar] [CrossRef]
- Jeengar, M.K.; Rompicharla, S.V.; Shrivastava, S.; Chella, N.; Shastri, N.R.; Naidu, V.G.; Sistla, R. Emu oil based nano-emulgel for topical delivery of curcumin. Int. J. Pharm. 2016, 506, 222–236. [Google Scholar] [CrossRef] [PubMed]
- Sideek, S.A.; El-Nassan, H.B.; Fares, A.R.; ElMeshad, A.N.; Elkasabgy, N.A. Different Curcumin-Loaded Delivery Systems for Wound Healing Applications: A Comprehensive Review. Pharmaceutics 2022, 15, 38. [Google Scholar] [CrossRef] [PubMed]
- Omidian, H.; Wilson, R.L.; Chowdhury, S.D. Enhancing Therapeutic Efficacy of Curcumin: Advances in Delivery Systems and Clinical Applications. Gels 2023, 9, 596. [Google Scholar] [CrossRef] [PubMed]
- Ouyang, Y.; Zhao, Y.; Zheng, X.; Zhang, Y.; Zhao, J.; Wang, S.; Gu, Y. Rapidly degrading and mussel-inspired multifunctional carboxymethyl chitosan/montmorillonite hydrogel for wound hemostasis. Int. J. Biol. Macromol. 2023, 242, 124960. [Google Scholar] [CrossRef] [PubMed]
- Dokovic, J.B.; Savic, S.M.; Mitrovic, J.R.; Nikolic, I.; Markovic, B.D.; Randjelovic, D.V.; Antic-Stankovic, J.; Bozic, D.; Cekic, N.D.; Stevanovic, V.; et al. Curcumin Loaded PEGylated Nanoemulsions Designed for Maintained Antioxidant Effects and Improved Bioavailability: A Pilot Study on Rats. Int. J. Mol. Sci. 2021, 22, 7991. [Google Scholar] [CrossRef]
- Bektas, N.; Senel, B.; Yenilmez, E.; Ozatik, O.; Arslan, R. Evaluation of wound healing effect of chitosan-based gel formulation containing vitexin. Saudi Pharm. J. 2020, 28, 87–94. [Google Scholar] [CrossRef]
- Yang, X.; Wang, S.; Zhang, X.; Ye, C.; Wang, S.; An, X. Development of PVA-based microsphere as a potential embolization agent. Mater. Sci. Eng. C Mater. Biol. Appl. 2022, 135, 112677. [Google Scholar] [CrossRef]
- Scomoroscenco, C.; Teodorescu, M.; Raducan, A.; Stan, M.; Voicu, S.N.; Trica, B.; Ninciuleanu, C.M.; Nistor, C.L.; Mihaescu, C.I.; Petcu, C.; et al. Novel Gel Microemulsion as Topical Drug Delivery System for Curcumin in Dermatocosmetics. Pharmaceutics 2021, 13, 505. [Google Scholar] [CrossRef]
- U.S. Food and Drug Administration. Inactive Ingredient Search for Approved Drug Products. Available online: https://www.accessdata.fda.gov/scripts/cder/iig/index.cfm (accessed on 27 August 2023).
- U.S. Food and Drug Administration. SCOGS (Select Committee on GRAS Substances). Available online: https://www.cfsanappsexternal.fda.gov/scripts/fdcc/?set=SCOGS (accessed on 27 August 2023).
- Thomas, L.; Zakir, F.; Mirza, M.A.; Anwer, M.K.; Ahmad, F.J.; Iqbal, Z. Development of Curcumin loaded chitosan polymer based nanoemulsion gel: In vitro, ex vivo evaluation and in vivo wound healing studies. Int. J. Biol. Macromol. 2017, 101, 569–579. [Google Scholar] [CrossRef]
- Ho, H.N.; Le, H.H.; Le, T.G.; Duong, T.H.A.; Ngo, V.Q.T.; Dang, C.T.; Nguyen, V.M.; Tran, T.H.; Nguyen, C.N. Formulation and characterization of hydroxyethyl cellulose-based gel containing metronidazole-loaded solid lipid nanoparticles for buccal mucosal drug delivery. Int. J. Biol. Macromol. 2022, 194, 1010–1018. [Google Scholar] [CrossRef] [PubMed]
- Clinical and Laboratory Standards Institute. Performance standards for antimicrobial susceptibility testing. In CLSI Supplement M100; CLSI: Wayne, PA, USA, 2020. [Google Scholar]

| Excipient Type | Excipient | CUR Solubility (mg/g) (Mean ± SD, n = 3) |
|---|---|---|
| Oils | Oleic acid | 0.17 ± 0.01 |
| Capryol 90 | 6.24 ± 0.37 | |
| Surfactants | Labrafil | 2.19 ± 0.42 |
| Labrasol | 52.49 ± 4.07 | |
| Cremophor RH40 | 42.95 ± 2.54 | |
| LS:CRH40 (1:1) | 48.11 ± 3.42 | |
| Co-surfactants | Propylene glycol | 0.97 ± 0.09 |
| Lauroglycol | 3.38 ± 0.18 |
| Excipients | VCapryol 90 (µL) (Mean ± SD, n = 3) | Emulsification Capability | |
|---|---|---|---|
| Labrafil | Surfactant | 10.00 ± 0.00 | Partial emulsification |
| Labrasol | Surfactant | 53.33 ± 5.77 | Complete emulsification |
| LS:CRH40 | Surfactant | 90.00 ± 10.00 | Complete emulsification |
| Propylene glycol | Co-surfactant | 26.67 ± 5.77 | Partial emulsification |
| Lauroglycol | Co-surfactant | 13.33 ± 5.77 | Partial emulsification |
| Input Values | Symbol | Variation Range | |
|---|---|---|---|
| Low Level (%) | High Level (%) | ||
| % Capryol 90 | X1 | 5 | 15 |
| % Smix | X2 | 45 | 65 |
| % water | X3 | 30 | 40 |
| Constraint condition | X1 + X2 + X3 = 100% | ||
| Output values | Constraints | ||
| Size (nm) | Y1 | Minimum | |
| Polydispersity index (PDI) | Y2 | Minimum | |
| No. | X1 (%) | X2 (%) | X3 (%) | Size (nm) | PDI |
|---|---|---|---|---|---|
| 1 | 15 | 50 | 35 | 32.91 ± 0.48 | 0.318 ± 0.016 |
| 2 | 7.5 | 55 | 37.5 | 17.73 ± 1.98 | 0.552 ± 0.149 |
| 3 | 12.5 | 55 | 32.5 | 33.81 ± 2.54 | 0.425 ± 0.030 |
| 4 | 15 | 45 | 40 | 27.96 ± 0.81 | 0.384 ± 0.039 |
| 5 | 10 | 60 | 30 | 26.03 ± 1.01 | 0.482 ± 0.049 |
| 6 | 12.5 | 50 | 37.5 | 26.94 ± 1.43 | 0.452 ± 0.061 |
| 7 | 5 | 55 | 40 | 69.12 ± 9.92 | 0.622 ± 0.287 |
| 8 | 7.5 | 60 | 32.5 | 20.65 ± 0.32 | 0.658 ± 0.115 |
| 9 | 5 | 65 | 30 | 28.62 ± 4.10 | 0.475 ± 0.018 |
| 10 | 10 | 50 | 40 | 20.77 ± 0.27 | 0.592 ± 0.067 |
| 11 | 10 | 55 | 35 | 28.04 ± 2.42 | 0.396 ± 0.018 |
| 12 | 15 | 55 | 30 | 39.02 ± 0.69 | 0.338 ± 0.014 |
| Output Variables | R2 | R2adj | R2pre | F-Value | p-Value |
|---|---|---|---|---|---|
| Y1 (Size) | 0.7130 | 0.5490 | −0.9963 | 4.35 | 0.0443 |
| Y2 (PDI) | 0.7009 | 0.6345 | 0.4709 | 10.55 | 0.0044 |
| Tested Bacteria | Inhibition Zone (mm) | ||||||||||
|---|---|---|---|---|---|---|---|---|---|---|---|
| CUR | CUR-NE | CUR Gel | CUR-NE Gel | Commercial Gel | Ampicillin | ||||||
| 350 µg/mL | 700 µg/mL | 350 µg/mL | 700 µg/mL | 350 µg/mL | 700 µg/mL | 350 µg/mL | 700 µg/mL | 350 µg/mL | 700 µg/mL | 10 µg | |
| S. aureus | N | N | 7.5 ± 0.4 | 9.5 ± 0.5 | N | N | 6.6 ± 0.1 | 7.8 ± 0.5 | 6.3 ± 0.1 | 6.5 ± 0.1 | 21.0 ± 0.1 |
| E. coli | N | N | 6.5 ± 0.1 | 10.8 ± 0.4 | N | N | 6.2 ± 0.3 | 8.6 ± 0.4 | N | 6.2 ± 0.1 | 18.4 ± 0.1 |
Disclaimer/Publisher’s Note: The statements, opinions and data contained in all publications are solely those of the individual author(s) and contributor(s) and not of MDPI and/or the editor(s). MDPI and/or the editor(s) disclaim responsibility for any injury to people or property resulting from any ideas, methods, instructions or products referred to in the content. |
© 2023 by the authors. Licensee MDPI, Basel, Switzerland. This article is an open access article distributed under the terms and conditions of the Creative Commons Attribution (CC BY) license (https://creativecommons.org/licenses/by/4.0/).
Share and Cite
Le, T.T.N.; Nguyen, T.K.N.; Nguyen, V.M.; Dao, T.C.M.; Nguyen, H.B.C.; Dang, C.T.; Le, T.B.C.; Nguyen, T.K.L.; Nguyen, P.T.T.; Dang, L.H.N.; et al. Development and Characterization of a Hydrogel Containing Curcumin-Loaded Nanoemulsion for Enhanced In Vitro Antibacteria and In Vivo Wound Healing. Molecules 2023, 28, 6433. https://doi.org/10.3390/molecules28176433
Le TTN, Nguyen TKN, Nguyen VM, Dao TCM, Nguyen HBC, Dang CT, Le TBC, Nguyen TKL, Nguyen PTT, Dang LHN, et al. Development and Characterization of a Hydrogel Containing Curcumin-Loaded Nanoemulsion for Enhanced In Vitro Antibacteria and In Vivo Wound Healing. Molecules. 2023; 28(17):6433. https://doi.org/10.3390/molecules28176433
Chicago/Turabian StyleLe, Thi Thanh Ngoc, Thi Kieu Nhi Nguyen, Van Minh Nguyen, Thi Cam Minh Dao, Hoai Bao Chau Nguyen, Cong Thuan Dang, Thi Bao Chi Le, Thi Khanh Linh Nguyen, Phuong Thao Tien Nguyen, Le Hoang Nam Dang, and et al. 2023. "Development and Characterization of a Hydrogel Containing Curcumin-Loaded Nanoemulsion for Enhanced In Vitro Antibacteria and In Vivo Wound Healing" Molecules 28, no. 17: 6433. https://doi.org/10.3390/molecules28176433
APA StyleLe, T. T. N., Nguyen, T. K. N., Nguyen, V. M., Dao, T. C. M., Nguyen, H. B. C., Dang, C. T., Le, T. B. C., Nguyen, T. K. L., Nguyen, P. T. T., Dang, L. H. N., Doan, V. M., & Ho, H. N. (2023). Development and Characterization of a Hydrogel Containing Curcumin-Loaded Nanoemulsion for Enhanced In Vitro Antibacteria and In Vivo Wound Healing. Molecules, 28(17), 6433. https://doi.org/10.3390/molecules28176433

